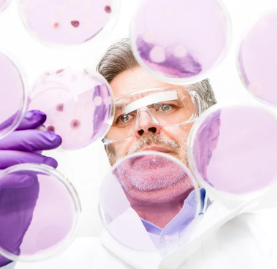
image.png

干細(xì)胞在未來醫(yī)療中有哪些突破性應(yīng)用?其治療潛力如何體現(xiàn)?
2024-10-11 15:48:47 來源: 小編 咨詢醫(yī)生
干細(xì)胞技術(shù)在近年來得到了廣泛的關(guān)注,其潛力巨大,為未來醫(yī)療領(lǐng)域帶來了許多突破性應(yīng)用。干細(xì)胞具有自我更新和分化為各種細(xì)胞類型的能力,這使得它們?cè)谂R床治療、藥物開發(fā)以及再生醫(yī)學(xué)等領(lǐng)域具有廣泛的應(yīng)用前景。以下是干細(xì)胞在未來醫(yī)療中的幾個(gè)突破性應(yīng)用及其治療潛力體現(xiàn)。
一、神經(jīng)系統(tǒng)疾病的治療
干細(xì)胞技術(shù)在神經(jīng)系統(tǒng)疾病治療方面具有巨大的潛力。例如,帕金森病、阿爾茨海默病等神經(jīng)退行性疾病,目前尚無根治方法。而干細(xì)胞技術(shù)可以通過誘導(dǎo)干細(xì)胞分化為神經(jīng)元,替換受損的神經(jīng)元,達(dá)到治療目的。此外,干細(xì)胞還能分泌神經(jīng)營(yíng)養(yǎng)因子,促進(jìn)神經(jīng)細(xì)胞的生長(zhǎng)和修復(fù)。
二、心血管疾病的治療
心血管疾病是全球死亡率最高的疾病之一。干細(xì)胞技術(shù)在心血管疾病治療方面取得了顯著成果。研究人員發(fā)現(xiàn),干細(xì)胞可以分化為心肌細(xì)胞、內(nèi)皮細(xì)胞和平滑肌細(xì)胞,從而修復(fù)受損的心血管組織。此外,干細(xì)胞還能促進(jìn)血管新生,改善心肌供血,提高心臟功能。
三、骨關(guān)節(jié)疾病的治療
骨關(guān)節(jié)疾病如骨壞死、股骨頭缺血性壞死等疾病,給患者帶來了極大的痛苦。干細(xì)胞技術(shù)在骨關(guān)節(jié)疾病治療方面也取得了突破性進(jìn)展。研究表明,干細(xì)胞可以分化為骨細(xì)胞、軟骨細(xì)胞和脂肪細(xì)胞,修復(fù)受損的骨關(guān)節(jié)組織。此外,干細(xì)胞還能分泌多種生長(zhǎng)因子,促進(jìn)損傷組織的再生和修復(fù)。
四、肝臟疾病的治療
肝臟疾病如肝硬化、急性肝衰竭等疾病,嚴(yán)重威脅人類健康。干細(xì)胞技術(shù)在肝臟疾病治療方面具有顯著優(yōu)勢(shì)。研究表明,干細(xì)胞可以分化為肝細(xì)胞,替換受損的肝細(xì)胞,恢復(fù)肝臟功能。此外,干細(xì)胞還具有抗炎、免疫調(diào)節(jié)作用,有助于減輕肝臟炎癥反應(yīng),促進(jìn)肝臟再生。
五、免疫疾病的治療
自身免疫性疾病如系統(tǒng)性紅斑狼瘡、類風(fēng)濕性關(guān)節(jié)炎等,病因復(fù)雜,治療困難。干細(xì)胞技術(shù)在免疫疾病治療方面展示了良好的前景。干細(xì)胞可以調(diào)節(jié)免疫系統(tǒng),抑制自身免疫反應(yīng),減輕炎癥損傷。此外,干細(xì)胞還能分化為免疫細(xì)胞,修復(fù)受損的免疫系統(tǒng),提高機(jī)體免疫力。
總之,干細(xì)胞在未來醫(yī)療領(lǐng)域具有廣泛的應(yīng)用前景。隨著研究的深入,干細(xì)胞技術(shù)在治療多種疾病方面取得了突破性進(jìn)展。然而,干細(xì)胞治療仍面臨諸多挑戰(zhàn),如免疫排斥、安全性、倫理問題等。相信在不久的將來,隨著科技的不斷發(fā)展,干細(xì)胞技術(shù)將為人類健康事業(yè)作出更大的貢獻(xiàn)。
- 2024-11-06干細(xì)胞治療的意義和作用體現(xiàn)在哪些方面?
- 2024-11-10干細(xì)胞移植腎臟副作用有哪些表現(xiàn)
- 2024-11-03國(guó)際干細(xì)胞研究在江西有哪些突破?
- 2024-10-21蘋果干細(xì)胞功效有哪些案例?
- 2024-11-04目前干細(xì)胞研究現(xiàn)狀分析及發(fā)展前景
- 2024-10-15什么是成體干細(xì)胞,常見成體干細(xì)胞的特點(diǎn)及應(yīng)用
- 2024-10-10海免疫干細(xì)胞作用大嗎?如何發(fā)揮其潛力?
- 2024-09-13疫情時(shí)期干細(xì)胞技術(shù)有哪些優(yōu)勢(shì)
- 2024-10-01無錫醫(yī)美干細(xì)胞有何獨(dú)特功效,對(duì)比其他城市有何優(yōu)勢(shì)
- 2024-10-05干細(xì)胞醫(yī)院用處大嗎?哪家醫(yī)院干細(xì)胞移植更靠譜?
- 2024-09-19再生干細(xì)胞療法是什么,有效果嗎
- 2024-08-04臍帶干細(xì)胞存儲(chǔ)要多少錢,臍帶干細(xì)胞存儲(chǔ)流程
- 2024-09-16干細(xì)胞療法上市藥物,中國(guó)批準(zhǔn)的干細(xì)胞藥物
- 2024-10-10海免疫干細(xì)胞作用大嗎?如何發(fā)揮其潛力?
- 2024-08-28甲狀腺結(jié)節(jié)用干細(xì)胞療法有用嗎多少錢
- 2024-09-30干細(xì)胞填充眼袋凹陷效果好不好,與傳統(tǒng)方法有何區(qū)別
- 2024-09-18干細(xì)胞治療臨床了嗎,需要多少時(shí)間
- 2024-09-10采集自體干細(xì)胞的過程,自體采干細(xì)胞的步驟
